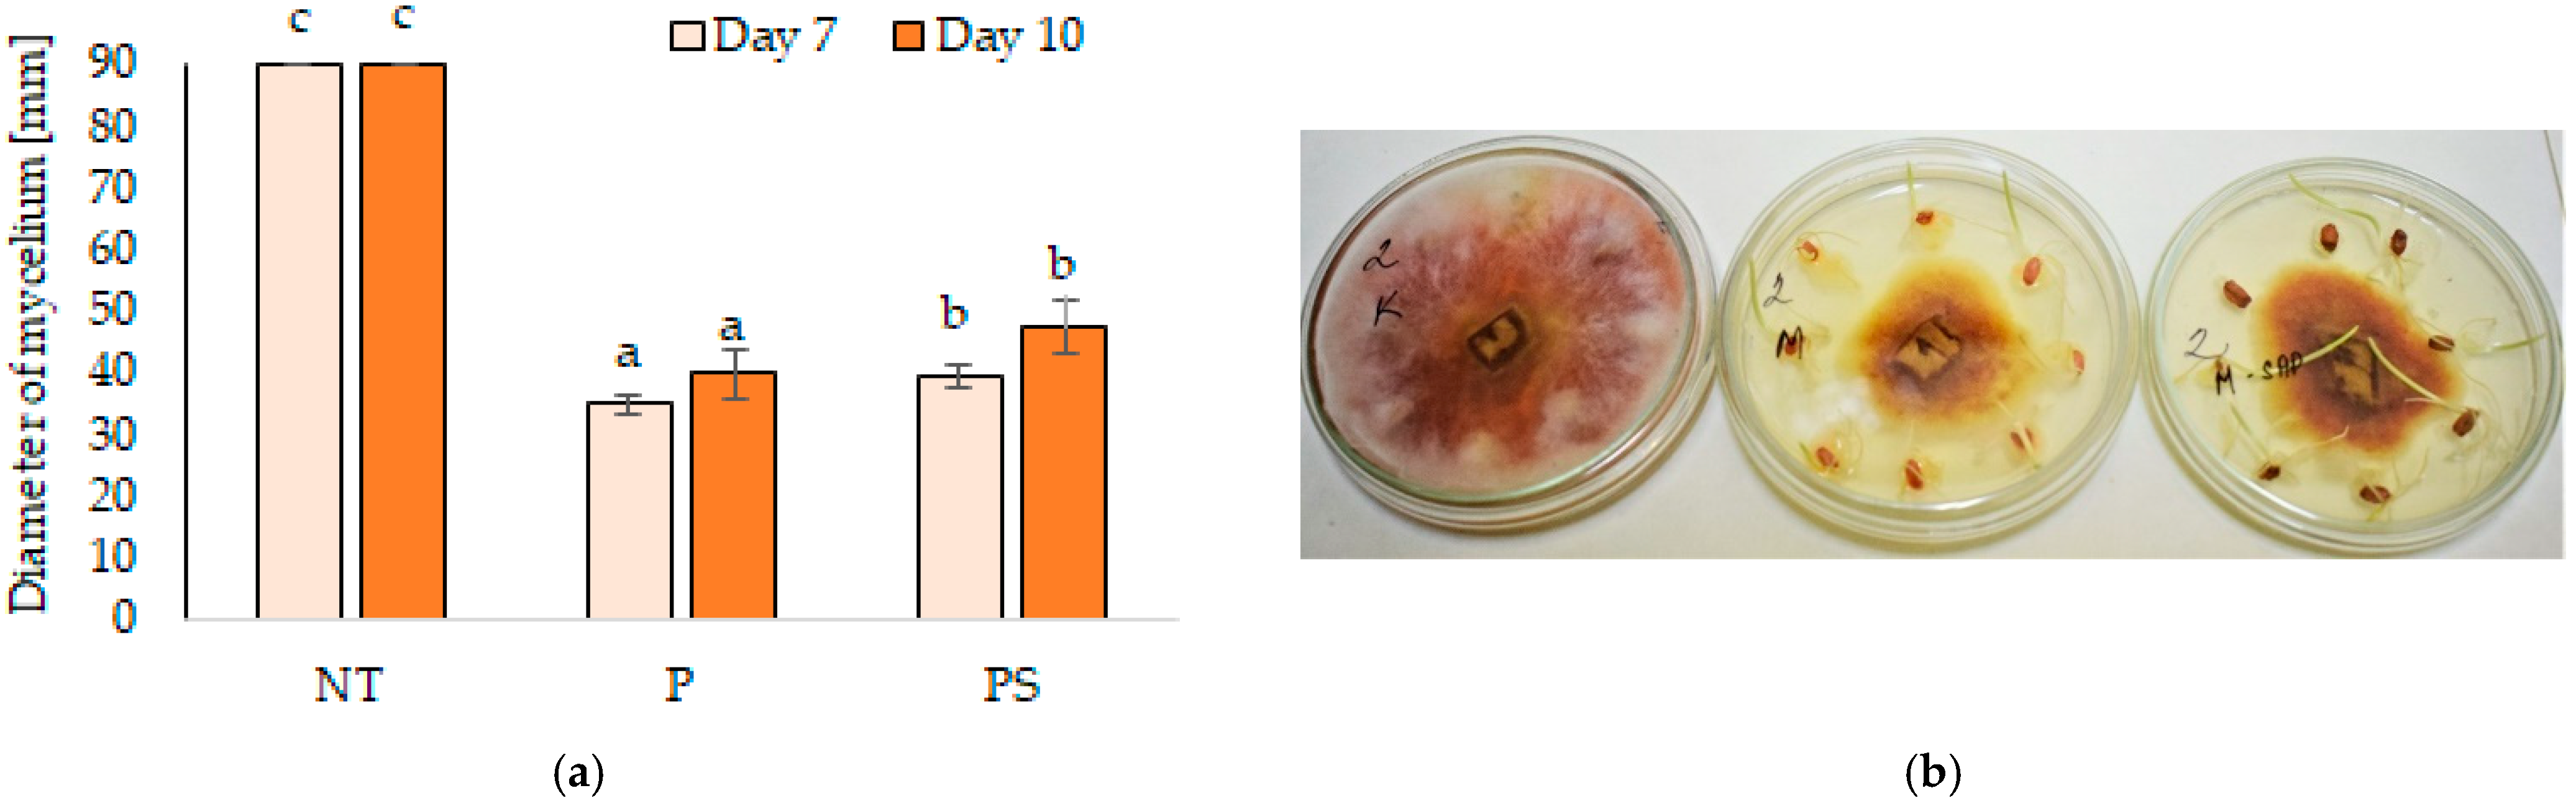

Superabsorbent Polymer Seed Coating Reduces Leaching of Fungicide but Does Not Alter Their Effectiveness in Suppressing Pathogen Infestation
Abstract
:1. Introduction
2. Materials and Methods
2.1. Biological Material
- Control seeds without any treatment (NT);
- Seeds coated with SAP (S);
- Seeds dressed with pesticides (P);
- Seeds dressed with pesticides and coated with SAP (PS).
2.2. In Vitro Test of Mycelium Growth Inhibition
2.3. Effect of Combined Seed Treatment with Pesticides and SAP on the Seed Germination in Soil Contaminated with F. culmorum
2.4. Quantitative Analysis of Fusarium DNA in Juvenile Plants
2.5. Statistical Analysis
3. Results
3.1. In Vitro Test of Mycelium Growth Inhibition
3.2. Effect of Combined Seed Treatment with Pesticides and SAP on Seed Germination in Soil Contaminated with F. culmorum
3.3. Quantitative Analysis of Fusarium DNA in Juvenile Plants
4. Discussion
5. Conclusions
Author Contributions
Funding
Conflicts of Interest
References
- Finch-Savage, W.E.; Bassel, G.W. Seed vigour and crop establishment: Extending performance beyond adaptation. J. Exp. Bot. 2016, 67, 567–591. [Google Scholar] [CrossRef] [Green Version]
- Lamichhane, J.R.; You, M.P.; Laudinot, V.; Barbetti, M.J.; Aubertot, J.-N. Revisiting sustainability of fungicide seed treatments for field crops. Plant Dis. 2020, 104, 610–623. [Google Scholar] [CrossRef] [Green Version]
- Fahad, S.; Bajwa, A.A.; Nazir, U.; Anjum, S.A.; Farooq, A.; Zohaib, A.; Sadia, S.; Nasim, W.; Adkins, S.; Saud, S.; et al. Crop production under drought and heat stress: Plant responses and management options. Front. Plant Sci. 2017, 8, 1147. [Google Scholar] [CrossRef] [PubMed] [Green Version]
- Sehgal, A.; Sita, K.; Siddique, K.H.M.; Kumar, R.; Bhogireddy, S.; Varshney, R.K.; HanumanthaRao, B.; Nair, R.M.; Prasad, P.V.V.; Nayyar, H. Drought or/and heat-stress effects on seed filling in food crops: Impacts on functional biochemistry, seed yields, and nutritional quality. Front. Plant Sci. 2018, 9, 1705. [Google Scholar] [CrossRef] [PubMed] [Green Version]
- Arora, N.K. Impact of climate change on agriculture production and its sustainable solutions. Environ. Sustain. 2019, 2, 95–96. [Google Scholar] [CrossRef] [Green Version]
- Rosero, A.; Granda, L.; Berdugo-Cely, J.A.; Šamajová, O.; Šamaj, J.; Cerkal, R. A dual strategy of breeding for drought tolerance and introducing drought-tolerant, underutilized crops into production systems to enhance their resilience to water deficiency. Plants 2020, 9, 1263. [Google Scholar] [CrossRef]
- Ali, A.; Erenstein, O. Assessing farmer use of climate change adaptation practices and impacts on food security and poverty in Pakistan. Clim. Risk Manag. 2017, 16, 183–194. [Google Scholar] [CrossRef]
- Tripathi, A. Superabsorbent polymers: Artificial mini water reservoirs in soil for agriculture applications. Acta Sci. Agric. 2018, 2, 1. [Google Scholar]
- Ekebafe, L.O.; Ogbeifun, D.E.; Okieimen, F.E. Polymer applications in agriculture. Biokemistri 2011, 23, 81–89. [Google Scholar]
- Peteu, S.F.; Oancea, F.; Sicuia, O.A.; Constantinescu, F.; Dinu, S. Responsive polymers for crop protection. Polymers 2010, 2, 229–251. [Google Scholar] [CrossRef] [Green Version]
- Milani, P.; França, D.; Balieiro, A.G.; Faez, R. Polymers and its applications in agriculture. Polímeros 2017, 27, 256–266. [Google Scholar] [CrossRef]
- Akhter, J.; Mahmood, K.; Malik, K.; Mardan, A.; Ahmad, M.; Iqbal, M.M. Effects of hydrogel amendment on water storage of sandy loam and loam soils and seedling growth of barley, wheat and chickpea. Plant Soil Environ. 2004, 50, 463–469. [Google Scholar] [CrossRef] [Green Version]
- Yazdani, F.; Allahdadi, I.; Akbari, G.A. Impact of Superabsorbent Polymer on Yield and Growth Analysis of Soybean (Glycine max L.) under Drought Stress Condition. Pak. J. Biol. Sci. 2008, 10, 4190–4196. [Google Scholar] [CrossRef] [PubMed] [Green Version]
- Montesano, F.F.; Parente, A.; Santamaria, P.; Sannino, A.; Serio, F. Biodegradable superabsorbent hydrogel increaseswater retention properties of growing media and plant growth. Agric. Agric. Sci. Proc. 2015, 4, 451–458. [Google Scholar] [CrossRef] [Green Version]
- Gunes, A.; Kıtır, N.; Turan, M.; Elkoca, E.; Yildirim, E.; Avci, N. Evaluation of effects of water-saving superabsorbent polymer on corn (Zea mays L.) yield and phosphorus fertilizer efficiency. Turk. J. Agric. For. 2016, 40, 365–378. [Google Scholar] [CrossRef]
- Abrisham, E.S.; Jafari, M.; Tavili, A.; Rabii, A.; Zare Chahoki, M.A.; Zare, S.; Egan, T.; Yazdanshenas, H.; Ghasemian, D.; Tahmoures, M. Effects of a super absorbent polymer on soil properties and plant growth for use in land reclamation. Arid Land Res. Manag. 2018, 32, 407–420. [Google Scholar] [CrossRef] [Green Version]
- Nagaraj Gokavi, R.; Mote, K.; Mukharib, D.S.; Manjunath, A.N.; Raghuramulu, Y. Performance of hydrogel on seed germination and growth of young coffee seedlings in nursery. J. Pharmacogn. Phytochem. 2018, 7, 1364–1366. [Google Scholar]
- Guan, Y.; Cui, H.; Ma, W.; Zheng, Y.; Tian, Y.; Hu, J. An enhanced drought-tolerant method using SA-loaded PAMPS polymer materials applied on tobacco pelleted seeds. Sci. World J. 2014, 2014, 752658. [Google Scholar] [CrossRef]
- Su, L.; Li, J.; Xue, H.; Wang, X. Super absorbent polymer seed coatings promote seed germination and seedling growth of Caragana korshinskii in drought. J. Zhejiang Univ.-Sci. B 2017, 18, 696–706. [Google Scholar] [CrossRef] [Green Version]
- Keawkham, T.; Siri, B.; Hynes, R.K. Effect of polymer seed coating and seed dressing with pesticides on seed quality and storability of hybrid cucumber. Aust. J. Crop Sci. 2014, 8, 1415–1420. [Google Scholar] [CrossRef]
- Pathak, V.; Ambrose, R.P.K. Starch-based biodegradable hydrogel as seed coating for corn to improve early growth under water shortage. J. Appl. Polym. Sci. 2020, 137, 48523. [Google Scholar] [CrossRef]
- Jarecki, W.; Wietecha, J. Effect of seed coating on the yield of soybean Glycine max (L.) Merr. Plant Soil Environ. 2021, 67, 468–473. [Google Scholar] [CrossRef]
- Pačuta, V.; Rašovský, M.; Michalska-Klimczak, B.; Wyszyňski, Z. Impact of Superabsorbent Polymers and Variety on Yield, Quality and Physiological Parameters of the Sugar Beet (Beta vulgaris prov. Altissima Doell). Plants 2021, 10, 757. [Google Scholar] [CrossRef]
- Ludwig, E.J.; Nunes, U.R.; Prestes, O.D.; Fagundes, L.K.; Fernandes, T.S.; Saibt, N. Polymer coating in soybean seed treatment and their relation to leaching of chemicals. Rev. Ambient. Agua 2020, 15, 2602. [Google Scholar] [CrossRef]
- Fagundes, L.K.; Nunes, U.R.; Prestes, O.D.; Fernandes, T.S.; Ludwig, E.J.; Saibt, N. Rice seed treatment and recoating with polymers: Physiological quality and retention of chemical products. Rev. Caatinga 2017, 30, 920–927. [Google Scholar] [CrossRef] [Green Version]
- Park, W.-P.; Chang, K.-M.; Hyun, H.-N.; Boo, K.-H.; Koo, B.-J. Sorption and leaching characteristics of pesticides in volcanic ash soils of Jeju Island, Korea. Appl. Biol. Chem. 2020, 63, 71. [Google Scholar] [CrossRef]
- Roy, A.; Singh, S.; Bajpai, J.; Bajpai, A. Controlled pesticide release from biodegradable polymers. Open Chem. 2014, 12, 453–469. [Google Scholar] [CrossRef]
- Kumar, J.; Nisar, K.; Arun Kumar, M.B.; Valia, S.; Shakil, N.A.; Prasad, R.; Parman, B. Development of polymeric seed coats for seed quality enhancement of soybean (Glycine max). Indian J. Agric. Sci. 2007, 77, 738–743. [Google Scholar]
- Vijaya Mahantesh, B.N.; Rai, P.K.; Srivastava, D.K.; Bara, B.M.; Kumar, R. Effects of polymer seed coating, fungicide seed treatment and storage duration on seedling characteristics of cotton (Gossypium hirsutum) seeds. J. Pharmacogn. Phytochem. 2017, 6, 534–536. [Google Scholar]
- Manoharapaladagu, P.V.; Rai, P.K.; Kumar, R.; Srivastava, D.K. Effects of polymer seed coating, fungicide seed treatment and packaging materials on seed quality of chilli (Capsicum annuum L.) during storage. J. Pharmacogn. Phytochem. 2017, 6, 324–327. [Google Scholar]
- Bleša, D.; Matušinský, P.; Sedmíková, R.; Baláž, M. The potential of Rhizoctonia-like fungi for the biological protection of cereals against fungal pathogens. Plants 2021, 10, 349. [Google Scholar] [CrossRef] [PubMed]
- Scherm, B.; Balmas, V.; Spanu, F.; Pani, G.; Delogu, G.; Pasquali, M.; Migheli, Q. Fusarium culmorum: Causal agent of foot and root rot and head blight on wheat. Mol. Plant Pathol. 2013, 14, 323–341. [Google Scholar] [CrossRef]
- Wang, Q.; Gottwald, S. Wheat root-dip inoculation with Fusarium graminearum and assessment of root rot disease severity. Bio-protocol 2017, 7, 2189. [Google Scholar] [CrossRef] [PubMed]
- Koch, E.; Zink, P.; Pfeiffer, T.; von Galen, A.; Linkies, A.; Drechsel, J.; Birr, T. Artificial inoculation methods for testing microorganisms as control agents of seed- and soil-borne Fusarium-seedling blight of maize. J. Plant Dis. Prot. 2020, 127, 883–893. [Google Scholar] [CrossRef]
- Antalová, Z.; Bleša, D.; Martinek, P.; Matušinsky, P. Transcriptional analysis of wheat seedlings inoculated with Fusarium culmorum under continual exposure to disease defence inductors. PLoS ONE 2020, 15, 0224413. [Google Scholar] [CrossRef]
- Qi, D.; Zou, L.; Zhou, D.; Chen, Y.; Gao, Z.; Feng, R.; Zhang, M.; Li, K.; Xie, J.; Wang, W. Taxonomy and broad-spectrum antifungal activity of streptomyces sp. Sca3-4 isolated from rhizosphere soil of Opuntia stricta. Front. Microbiol. 2019, 10, 1390. [Google Scholar] [CrossRef] [PubMed]
- Leišová, L.; Kučera, L.; Chrpová, J.; Sýkorová, S.; Šíp, V.; Ovesná, J. Quantification of Fusarium culmorum in wheat and barley tissues using Real-Time PCR in comparison with DON content. J. Phytopathol. 2006, 154, 603–611. [Google Scholar] [CrossRef]
- Dehkordi, D.K. The Effects of Superabsorbent Polymers on Soils and Plants. Pertanika J. Trop. Agric. Sci. 2016, 39, 267–298. [Google Scholar]
- Afzal, I.; Javed, T.; Amirkhani, M.; Taylor, A.G. Modern seed technology: Seed coating delivery systems for enhancing seed and crop performance. Agriculture 2020, 10, 526. [Google Scholar] [CrossRef]
- Avelar, S.A.G.; de Sousa, F.V.; Fiss, G.; Baudet, L.; Peske, S.T. The use of film coating on the performance of treated corn seed. Rev. Bras. Sementes 2012, 34, 186–192. [Google Scholar] [CrossRef] [Green Version]
- Elshafie, H.S.; Camele, I. Applications of Absorbent Polymers for Sustainable Plant Protection and Crop Yield. Sustainability 2021, 13, 3253. [Google Scholar] [CrossRef]
- Rocha, I.; Ma, Y.; Souza-Alonso, P.; Vosátka, M.; Freitas, H.; Oliveira, R.S. Seed coating: A tool for delivering beneficial microbes to agricultural crops. Front. Plant Sci. 2019, 10, 1357. [Google Scholar] [CrossRef] [Green Version]
- Kimmelshue, C.; Goggi, A.S.; Cademartiri, R. The use of biological seed coatings based on bacteriophages and polymers against Clavibacter michiganensis subsp. Nebraskensis in maize seeds. Sci. Rep. 2019, 9, 17950. [Google Scholar] [CrossRef]
- Xiong, B.; Loss, R.D.; Shields, D.; Pawlik, T.; Hochreiter, R.; Zydney, A.L.; Kumar, M. Polyacrylamide degradation and its implications in environmental systems. npj Clean Water 2018, 1, 17. [Google Scholar] [CrossRef]
- Nyyssölä, A.; Ahlgren, J. Microbial degradation of polyacrylamide and the deamination product polyacrylate. Int. Biodeterior. Biodegr. 2019, 139, 24–33. [Google Scholar] [CrossRef]
- Joshi, S.J.; Abed, R.M.M. Biodegradation of polyacrylamide and its derivatives. Environ. Process. 2017, 4, 463–476. [Google Scholar] [CrossRef]
- Oksińska, M.P.; Magnucka, E.G.; Lejcuś, K.; Pietr, S.J. Biodegradation of the cross-linked copolymer of acrylamide and potassium acrylate by soil bacteria. Environ. Sci. Pollut. Res. 2016, 23, 5969–5977. [Google Scholar] [CrossRef] [PubMed]
- Sikder, A.; Pearce, A.K.; Parkinson, S.J.; Napier, R.; O’Reilly, R.K. Recent trends in advanced polymer materials in agriculture related applications. ACS Appl. Polym. Mater. 2021, 3, 1203–1217. [Google Scholar] [CrossRef]
- Capezza, A.J.; Newson, W.R.; Olsson, R.T.; Hedenqvist, M.S.; Johansson, E. Advances in the use of protein-based materials: Toward sustainable naturally sourced absorbent materials. ACS Sustain. Chem. Eng. 2019, 7, 4532–4547. [Google Scholar] [CrossRef]
- Capezza, A.J.; Muneer, F.; Prade, T.; Newson, W.R.; Das, O.; Lundman, M.; Olsson, R.T.; Hedenqvist, M.S.; Johansson, E. Acylation of agricultural protein biomass yields biodegradable superabsorbent plastics. Commun. Chem. 2021, 4, 52. [Google Scholar] [CrossRef]
- Jiménez-Rosado, M.; Perez-Puyana, V.; Cordobés, F.; Romero, A.; Guerrero, A. Development of superabsorbent soy protein—Based bioplastic matrices with incorporated zinc for horticulture. J. Sci. Food Agric. 2019, 99, 4825–4832. [Google Scholar] [CrossRef] [PubMed]

| Seed Treatment | NT | S | P | PS |
|---|---|---|---|---|
| Inoculation | Maize | |||
| Control | 91.7 ± 16.7 abc | 91.7 ± 9.6 abc | 100 ± 0.0 a | 95.8 ± 8.3 ab |
| Inoculation I | 66.7 ± 16.7 ef | 77.8 ± 9.6 cde | 100 ± 0.0 a | 100 ± 0.0 a |
| Inoculation II | 55.6 ± 9.6 f | 88.9 ± 9.6 abc | 94.4 ± 9.6 ab | 88.9 ± 9.62 abc |
| Inoculation III | 66.7 ± 16.7 ef | 72.2 ± 9.6 de | 94.4 ± 9.6 ab | 100 ± 0.0 a |
| Wheat | ||||
| Control | 85.0 ± 5.7 a | 85.0 ± 10.0 a | 90.0 ± 14.1 a | 82.5 ± 5.0 ab |
| Inoculation I | 0.0 g | 0.0 g | 90.0 ± 10.0 a | 63.3 ± 11.6 cd |
| Inoculation II | 0.0 g | 0.0 g | 93.3 ± 5.8 a | 66.7 ± 15.3 bcd |
| Inoculation III | 50.0 ± 20.0 d | 76.7 ± 15.3 abc | 83.3 ± 11.6 ab | 86.7 ± 5.8 a |
Publisher’s Note: MDPI stays neutral with regard to jurisdictional claims in published maps and institutional affiliations. |
© 2021 by the authors. Licensee MDPI, Basel, Switzerland. This article is an open access article distributed under the terms and conditions of the Creative Commons Attribution (CC BY) license (https://creativecommons.org/licenses/by/4.0/).
Share and Cite
Gubišová, M.; Hudcovicová, M.; Matušinský, P.; Ondreičková, K.; Klčová, L.; Gubiš, J. Superabsorbent Polymer Seed Coating Reduces Leaching of Fungicide but Does Not Alter Their Effectiveness in Suppressing Pathogen Infestation. Polymers 2022, 14, 76. https://doi.org/10.3390/polym14010076
Gubišová M, Hudcovicová M, Matušinský P, Ondreičková K, Klčová L, Gubiš J. Superabsorbent Polymer Seed Coating Reduces Leaching of Fungicide but Does Not Alter Their Effectiveness in Suppressing Pathogen Infestation. Polymers. 2022; 14(1):76. https://doi.org/10.3390/polym14010076
Chicago/Turabian StyleGubišová, Marcela, Martina Hudcovicová, Pavel Matušinský, Katarína Ondreičková, Lenka Klčová, and Jozef Gubiš. 2022. "Superabsorbent Polymer Seed Coating Reduces Leaching of Fungicide but Does Not Alter Their Effectiveness in Suppressing Pathogen Infestation" Polymers 14, no. 1: 76. https://doi.org/10.3390/polym14010076
APA StyleGubišová, M., Hudcovicová, M., Matušinský, P., Ondreičková, K., Klčová, L., & Gubiš, J. (2022). Superabsorbent Polymer Seed Coating Reduces Leaching of Fungicide but Does Not Alter Their Effectiveness in Suppressing Pathogen Infestation. Polymers, 14(1), 76. https://doi.org/10.3390/polym14010076

